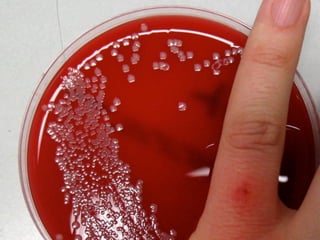

O documento discute o controle estatístico de processos e como ele pode ajudar a distinguir variações significativas de ruído aleatório em dados de processos. Ele sugere que o SPC pode ajudar a determinar quando uma variação é um sinal de mudança no processo versus quando é simplesmente aleatória.